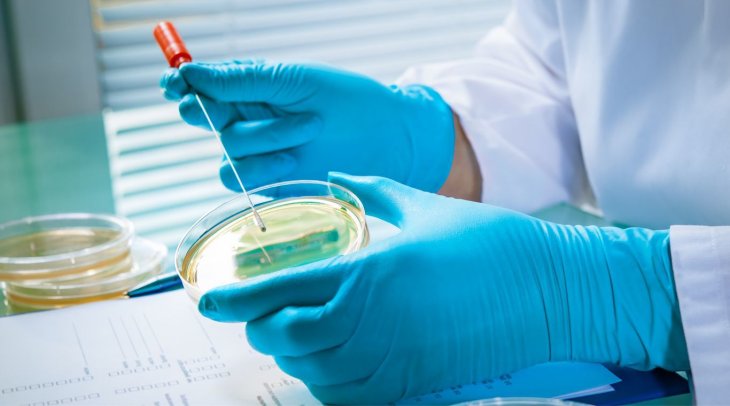
Медики виявили причину чоловічої безплідності

Медики виявили причину чоловічої безплідності
Таку причину фахівці вважають досить поширеною.
Вчені в рамках дослідження виявили ген, який може бути відповідальним за чоловіче безпліддя. Робота проводилася німецькими фахівцями з Університету Мюнстера.
Мутацію, яку жителі Європи могли успадкувати від загального предка, виявлено в гені M1AP. Вивчивши дані про майже 2 тисячі безплідних чоловіків, автори дослідження виявили 14 осіб із різних країн, які мають зазначені зміни до M1AP. Мутації мали місце в обох батьківських генетичних копіях, а це має на увазі успадкування як від матері, так і від батька. Таке явище відоме як аутосомно-рецесивне успадкування, коли зміна дається взнаки, якщо обидві копії гена виявилися пошкоджені. За словами авторів роботи, їм вдалося знайти свідчення зв'язку вказаної мутації з безпліддям у чоловіків. До того ж таку причину фахівці вважають досить поширеною.
Поки що відсутня терапія, яка за такої проблеми могла б підвищити шанси на зачаття. У людей, що мають мутацію M1AP, гірше відбувається виробництво сперматозоїдів. Проте висновки дослідження є важливими, оскільки з його допомогою можна виявити причину безпліддя.
В Одесі російський дрон влетів у квартиру на 11 поверсі (відео)
На Одещині водій BMW, який перебував у розшуку, збив прикордонника під час спроби втечі (відео)
На Одещині чоловіка придавило бетонною плитою в покинутій будівлі (відео)
«Амур. Дубль два» - нова робота миколаївської художниці на тему «втечі із міськвиконкому» (фото, відео)
«Обличчя театру»: яскраві театральні особистості у роботах Ярослава Туріва (фото, відео)
Музика від серця та для душі: Еліна Образцова зіграла авторський концерт (фото, відео)
«Світло всередині нас»: Хореографічний колектив «Карамель» показав ювілейну програму (фото, видео)
Вийшов офіційний тизер документального фільму "Кузьма: Страшно веселий"
З'явилися фото та відео з місця обстрілу Миколаєва













